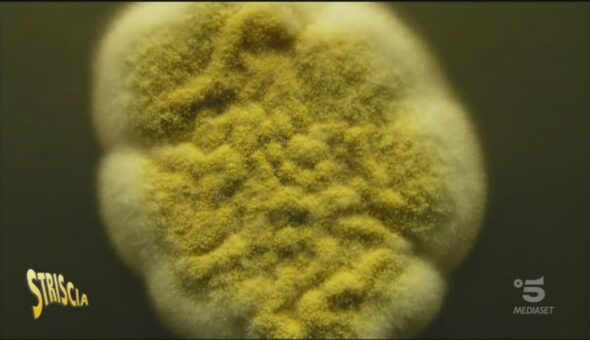

Puntata del 09/02/2019
Puntata
martedì
29.01
2019
mercoledì
30.01
2019
giovedì
31.01
2019
venerdì
01.02
2019
sabato
02.02
2019
lunedì
04.02
2019
martedì
05.02
2019
mercoledì
06.02
2019
giovedì
07.02
2019
venerdì
08.02
2019
sabato
09.02
2019
lunedì
11.02
2019
martedì
12.02
2019
mercoledì
13.02
2019
giovedì
14.02
2019
venerdì
15.02
2019
sabato
16.02
2019
lunedì
18.02
2019
martedì
19.02
2019
mercoledì
20.02
2019
giovedì
21.02
2019
Puntata di
sabato 9 febbraio
2019
i servizi
Striscia tra poco
- Università Antimafia
- Sosta corsia di emergenza a Fiumicino
- Le cipolle in Umbria
- Prosciutto cotto sotto esame
- Funghi contro l'inquinamento
- Brumotti very "Beautiful"
- Firenze, cartelli pubblicitari che distraggono
- Il San Valentino di Casanova
- Moda caustica a Sanremo 2019
I Servizi della Puntata
SOS Gabibbo!
Segnala ingiustizie, scandali o scoop al Gabibbo!